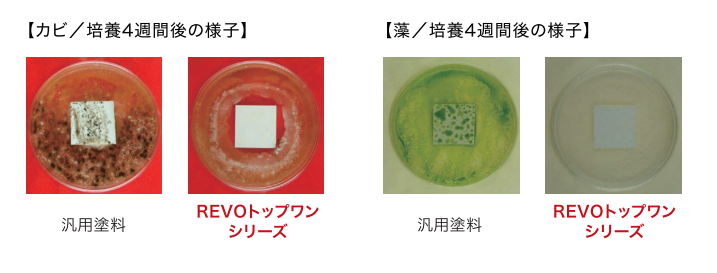

スタッフブログ
REVOトップワンシリーズの特徴・耐久性を徹底解説!
2026.02.03
スタッフブログ
塗料選び

外壁塗装で「なるべく工期を短くしたい」「長持ちする塗料を選びたい」
という方におすすめなのが、
アステックペイントの REVOトップワンシリーズ(REVOトップワンF/REVOトップワンSi) です。
REVOトップワンシリーズとは?
REVOトップワンシリーズは、
下塗りの役割と上塗りの性能を1つの塗料で兼ね備えている塗料です。

通常の塗装工程では、
・下塗り
・中塗り
・上塗り
それぞれの「3工程」が必要ですが、
REVOトップワンシリーズは
上塗り2回のみで完了する塗料となっています。
そのため
・工期短縮
・コスト削減
・高い耐久性を維持することができる
このようなメリットのある塗料となっています。
REVOトップワンシリーズの特徴とは?
①下塗りなしでもしっかりと密着

REVOトップワンシリーズには、
外壁にしっかりと密着する成分
「付着強化成分」が配合されています。

その結果、
- 下塗り材と同等の密着力
- サイディングとの強固な付着
- 上塗り2回だけで丈夫な塗膜を形成する
そのようなことが実現できます。

またサイディングボードの密着試験でも、
強固な密着力が確認されています。
②長持ちしやすい高耐候性

強い紫外線や雨を再現した試験では、
次のような耐久性が確認されています。
REVOトップワンF:約16~20年相当の耐候性
REVOトップワンSi:約13~16年相当の耐候性
このような高い結果が確認されています。
✔完全交互結合型フッ素樹脂(F)

✔劣化しにくい成分を豊富に配合(Si)

✔ラジカル制御型白色顔料(シリーズ共通)

外壁を痛める要因でもある「ラジカル」を抑えることから、
さらに長持ちしやすい塗料となっています。
③汚れが付きにくい低汚染性

雨で汚れが流れやすい特徴があります。
塗膜の表面が水に馴染みやすいため、
雨水が汚れを浮かせて洗い流し、雨筋汚れがつきにくい構造に。

6ヶ月間の屋外暴露試験を行った際、
REVOトップワンシリーズは
他社の塗料よりも、雨筋汚れが圧倒的に少ない結果となりました。
④防カビ・防藻性
「JIS Z 2911」のカビ抵抗性試験を行った際に、
社内の藻抵抗性試験のどちらもクリアしています。
一般塗料と比較して大幅に少ないことから、
北面や日当たりの悪い場所でも安心して過ごすことができます。
※株式会社アステックペイント HPより抜粋
REVOトップワンシリーズはこんな方におすすめ!
- 工期を短くしたい
- 下塗り不要の高品質塗料を選びたい
- 外壁を長持ちさせたい
- 雨筋などの汚れを防ぎたい
- カビや藻が出やすい環境に住んでいる
そんな方におすすめの塗料です。
またREVOトップワンシリーズは、
耐久性・美観保持・工期短縮のすべてを叶えたい方に最適な塗料です。
外壁塗装をご検討中の方は、ぜひお気軽にお問い合わせください!
現場調査・お見積りはすべて無料で行っております。
















